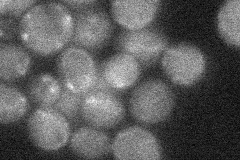
YLR393W

View description
Mitochondrial inner membrane protein required for assembly of the F0 sector of mitochondrial F1F0 ATP synthase, interacts genetically with ATP6
Localization:
Intensity:
Fold change:
Significance:
-
C’ GFP library in SD

mitochondria22.25 -
N' NOP1pr-GFP in SD

mitochondria55.9845 -
N' TEF2pr-mCherry in SD

mitochondria65.1924 -
N' NATIVEpr-GFP in SD
mitochondria21.1419 -
N' TEF2pr-VC and Cyto-VN in SD

#N/A0 -
C’ GFP library in SD+DTT

mitochondria22.050.99No -
C’ GFP library in SD+H2O2

mitochondria19.910.89No -
C’ GFP library in Starvation Media

mitochondria33.661.51Yes -
C’ GFP library on the background of Pup2-DaMP

mitochondria -
C’ GFP library on the background of CCT mutant

mitochondria19.85990.892117No
